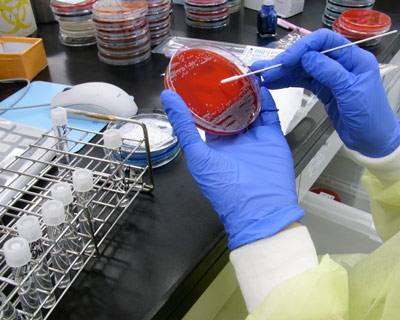
同定・感受性検査のようす

臨床検査部
患者さんにとって適切であり、
着実に診断・治療につながる
検査結果を迅速かつ正確に提供します。
役割と特徴
臨床検査部は、「病院技師」「外部委託技師(SRL)」「クラーク」で構成されています。
主な業務内容は、病院技師が生理検査、輸血検査、細菌検査、病理検査、中央採血、心臓カテーテル検査、内視鏡検査を担当。外部委託技師(SRL)は検体検査(生化学・血液・尿など)を行っています。
また、病院技師は細胞検査士、認定輸血検査技師、認定臨床微生物検査技師、認定超音波検査士(循環器、消化器・血管)、心血管インターベンション技師、消化器内視鏡技師などの専門資格を有し、多職種とともに業務連携しながら、患者さんにとって適切であり、着実に診断・治療に繋がる検査を日々行っています。
当院は、適切な輸血管理が行われているか否かを第三者によってinspection(点検)してaccreditation (認証)し、医療施設の輸血の安全性を保証する制度である輸血機能評価認定(I&A)の認定病院です。
各種検査について
生理検査
当院検査室では、各種心電図検査、運動負荷検査、超音波検査、末梢循環検査、呼吸機能検査、脳波検査、筋電図検査などを行っています。また心臓カテーテル検査やカテーテルアブレーションにも携わっています。
12誘導心電図
心臓から発生する微弱な電気信号の変化を心電計で記録したものです。
両手・両足・胸部に電極を装着し検査を行います。心筋梗塞や狭心症などの虚血性心疾患や不整脈などの診断に有用な検査です。
運動負荷心電図
運動を行うことで心臓に負荷を与え、安静時にはとらえられない心電図変化をみる検査です。虚血性心疾患の診断、心機能評価を目的として実施されます。
当院ではマスター負荷心電図、トレッドミル負荷心電図を行っています。
マスター負荷心電図
凸型の2階段を定められた速さ・時間で上り下りをし、運動前後で心電図を記録します。
昇降回数は性別、年齢、体重で決定されています。
トレッドミル負荷心電図
ベルトコンベア状の検査装置の上を歩いたり走ったりします。ベルトの速度と傾斜によって運動量を調節し、運動中の心電図・血圧をモニタリングしながら検査を行います。
加算平均心電図(レートポテンシャル)
通常の12誘導心電図では記録できない微小電位を記録し、心室遅延電位の有無を調べる検査です。微小電位を記録するため、通常の心電図検査より時間がかかります。
ホルター心電図
患者さんに携帯型の記録器を装着してもらい、日常生活での心電図を24時間記録します。 不整脈の診断、虚血性心疾患の診断に用います。
脈波
両手両足の血圧、心電図、心音図を同時に測定し、下肢動脈の狭窄や閉塞、動脈硬化の有無や程度を調べる検査です。
SPP(皮膚灌流圧)
皮膚組織レベルの毛細血管の血流を測定します。下肢虚血の重症度評価や難治性潰瘍の治癒予測に有用な検査です。
超音波検査
超音波検査は、簡便かつ非侵襲的な検査です。ゼリーをつけたプローブと呼ばれる超音波発信器を体に当てて検査を行います。
検査箇所は多岐にわたり、心臓領域、腹部領域、血管領域、婦人科領域、体表、関節(リウマチ)、透析シャント評価などを行っています。
心臓超音波検査
心臓の形態や大きさ、壁の厚さ、弁の形、血流などをリアルタイムで見ることができます。心疾患の診断や心機能評価を行います。
腹部超音波検査
肝臓、胆嚢、膵臓、腎臓、脾臓などの腹部臓器や、骨盤腔内の膀胱、子宮、前立腺などの臓器の形、大きさを検査します。臓器内での炎症反応、腫瘤病変の有無などの確認も行っています。
肺機能検査・特殊肺機能検査
息を吸ったり吐いたりして肺の大きさや息を吐く勢い、酸素を取り込む能力などを調べます。
呼気NO測定
呼気中の一酸化窒素 NO の濃度を測定する検査です。
脳波検査
頭に電極を装着し、脳の活動電位を記録します。安静にした状態で、覚醒・閉眼時の基本波形を記録します。また、開閉眼、光刺激、過呼吸、睡眠など賦活中の記録も行います。
筋電図検査
神経や筋肉の機能を調べる検査です。
検査には、針電極を用いて筋肉の状態を調べる針筋電図検査や、電気刺激を用いて運動神経や知覚神経の状態を調べる神経伝導検査などがあります。
心肺運動負荷試験(CPX)
自転車エルゴメーターを使用し負荷をかける検査です。医師立ち合いのもと心電図・血圧・呼気中の酸素・二酸化炭素をモニタリングしながら、心臓・肺・運動に使われる筋肉の状態を総合的にみて、どれだけ運動できるかを検査していきます。
心臓リハビリテーションを行う際にCPXを行い評価します。
心臓カテーテル検査
狭心症、急性心筋梗塞、弁膜症などの症例で心臓の冠動脈や左室造影などを行い血管が閉塞・狭窄していないかを検査し、治療を行います。カテーテル検査には様々な職種が携わっており、臨床検査技師は患者の心電図・血圧のモニタリングを行っています。


カテーテルアブレーション
カテーテルアブレーションは、心臓内部の不整脈の原因となる電気回路を遮断する、不整脈の代表的な治療方法です。
臨床検査技師は、術者が安全で正確な手技が行えるよう、波形や画像の解析を行い診断のサポートを行っています。
輸血検査
血液製剤の血液発注、入庫、保管管理を行い、血液型検査、不規則抗体検査、交差適合試験、自己血貯血の保管管理も行っています。また輸血監査ラウンドを各病棟で行い輸血療法が安全で適正に行われているかを確認・指導しています。

輸血ニュース
監査ラウンドで気になった事など輸血に関する情報を提供するために輸血ニュースを作成、院内に配信しています。


献血者確保対策
院内Webサイト、ホームページ、facebook、院内ポスターやキャンペーンなどを利用して、病院内外へ献血への協力をお願いしています。



細菌検査
感染症の原因となっている細菌・真菌を見つけ、その菌に有効な抗菌薬を調べたり 感染情報の発信源として院内の感染管理に役立つ情報をいち早く提供しています。
また、感染対策チームICT(ICT : Infection control team )の一員として、ICTラウンドや感染対策委員会に参加し他職種と連携することで、患者・職員・病院訪問者を感染から防御し、 安全な医療環境の提供に努めています。
塗抹・分離

グラム染色 鏡検
グラム染色・鏡検により菌の種類の鑑別を行います。


同定・感受性検査
培養して育てた細菌を用いて菌の種類を同定、その細菌に対してどのような抗菌薬が効くのか感受性の検査を行います。

感染対策チーム(ICT : Infection control team)としての活動
細菌検査室は感染対策チームICTの一員です。近森病院のアンチバイオグラムを作成し、感染症の初期治療の抗菌薬選択、薬剤耐性菌の動向を一目でチェックできるシートを作っています。
ICTラウンド 耐性菌ラウンド
ICTラウンドでは様々な職種のメンバーで週1回、現場の感染管理状況の監視、指導を行い、感染対策が適切なのかをチェックしています。
耐性菌ラウンドでは院内で発生している薬剤耐性菌の情報を提供することで、抗菌薬の適正使用のチェック、耐性菌患者に対する適正な感染対策が行われているかなどのチェックを行ないます。


病理検査
組織診断・術中迅速組織診断・細胞診断・病理解剖を行っています。
手術組織や生検組織から顕微鏡標本を作製し、癌などの病気を正確に診断しています。
病理組織診標本作製
病理医が組織診断をするための標本作製を行います。包埋、薄切、染色を行うことで、組織診断が可能な標本が出来上がります。


術中迅速組織診断
術中迅速組織診断では手術中に提出された検体から迅速に標本を作製し、良・悪性の鑑別や組織型の推定等を行います。


細胞診断
尿・喀痰・胸水・腹水・心嚢液・胆汁・膵液・気管支搾過物・乳腺・甲状腺など、全身の液体から臨床検査技師(細胞検査士)が顕微鏡で腫瘍細胞を見つけ報告します。
病理解剖
患者さんがご入院中にお亡くなりになられると、病気の原因や死因、病像や治療効果などについて、臓器や組織を直接観察して、より明らかにするために行われます。
取り出した臓器から、さらに顕微鏡標本を作製して最終診断します。
お亡くなりになられた患者さんから、病理解剖の検索を通して、医学や医療をさらに学ばせていただき、最善そして、最適の医療の実践を目指します。
院内CPC: Clinicopathological Conference
毎月第4木曜日17時15分~管理棟3階会議室
病理解剖後、臨床医と病理医がClinicopathological Conferenceを行い、病因の検討を行います。CPC参加者は、臨床医のほか近森病院職員(医事課、看護師、放射線技師、臨床検査技師など)や院外の医師、医療従事者よりなる“院内CPC”の形態です。研修医は指導医と共に主治医として対応しCPC後、臨床研修必須項目であるCPCレポートを作成提出しています。
迅速細胞診断(気管支鏡検査・EUS-FNAなど)
細胞検査士が検体採取する場に出向き、標本作製、迅速細胞診断にて悪性細胞があるかないかをその場で判断します。気管支鏡検査、EUS-FNAでは全例実施しています。
中央採血室
中央採血室では各科診療科から依頼される外来患者さんの血液検査のための採血を行います。
採血時には、患者さんご自身にてお名前と生年月日を名乗っていただくことで患者間違いを防止しています。


検体検査(外部委託SRL)
採血された生化学、血算、凝固などの検体や尿検査などは、各専用装置で測定し報告をしています。午前8時までに入院患者さんの検査を報告して、8時からは外来患者さんの検査を行います。
内視鏡検査
上・下部内視鏡検査、止血術、ERCP、気管支鏡検査、EMR、ESD、などの検査を担当しています。また緊急時の各種内視鏡検査では、24時間体制で対応しています。
内視鏡検査では生理技師(超音波検査士:心エコー、腹部エコー)、輸血技師、細菌技師(認定微生物検査技師)、病理技師(細胞検査士、認定病理検査技師)はそれぞれ、消化器内視鏡技師の資格も取得し、各自の専門性を生かして内視鏡検査と兼任しています。
検体採取から病理標本作製まで臨床検査技師が関わることで、良質な病理標本作製の向上・病理組織学的診断の向上につながっています。


メッセージ
臨床検査部では、医師、看護師、コメディカルスタッフと緊密な業務連携をとりながら、迅速かつ正確な検査結果を提供しています。また、日々変化する医療のなか、患者さんに良質で適切な医療が提供できるように日々精進しています。
専門資格について
当院では、専門性の高い知識を持つ多数の臨床検査技師が活躍しています。検査についてのご質問やご要望などございましたら、お気軽にお尋ねください。
| 日本臨床細胞学会 細胞検査士 | 5名 |
|---|---|
| 日本輸血・細胞治療学会 認定輸血検査技師 | 1名 |
| 日本臨床微生物学会 認定臨床微生物検査技師 | 4名 |
| 日本超音波医学会 認定超音波検査士(循環器) | 5名 |
| 日本超音波医学会 認定超音波検査士(消化器) | 7名 |
| 日本超音波医学会 認定超音波検査士(血管) | 6名 |
| 日本心血管インターベンション治療学会 心血管インターベンション技師 | 3名 |
| 日本消化器内視鏡学会 消化器内視鏡技師 | 14名 |
(2023年4月1日現在)
細胞検査士
人体のあらゆる細胞を顕微鏡で観察し、その細胞の変化から正常な細胞か癌細胞かを診断し、癌の早期発見、治療に繋げています。
認定輸血検査技師
輸血に関する正しい知識と的確な検査により、輸血を安全に提供できる専門業務を行っています。
認定臨床微生物検査技師
感染症の原因となっている菌(細菌や真菌)を検出し、その菌に有効な薬(抗菌薬)を検査しています。病院内で感染症や耐性菌(薬が効かない菌)が蔓延しないように院内の感染対策業務も行っています。
認定超音波検査士(循環器)
循環器超音波検査士は、心臓の動きや形態、弁の状態など超音波装置を用いて観察し、多くの心臓疾患(虚血性心疾患・弁膜症・心筋症・先天性心疾患など)の診断に関わる検査を行っています。
認定超音波検査士(消化器・血管)
腹部や血管に超音波を当てて、肝臓、胆嚢、膵臓、腎臓、脾臓、消化管、血管を超音波検査士が検査します。苦痛なく安全に検査を行い疾患の診断に関わる検査をしています。
心血管インターベンション技師
心臓の血管(冠動脈)や全身の血管の狭窄や閉塞を拡げる治療を行う際、安全でよりよい治療が行えるようサポートをしています。
消化器内視鏡技師
胃や大腸、膵・胆管などの内視鏡検査・治療の際に、機器管理や、前処置から検査中の介助など専門に行っています。
